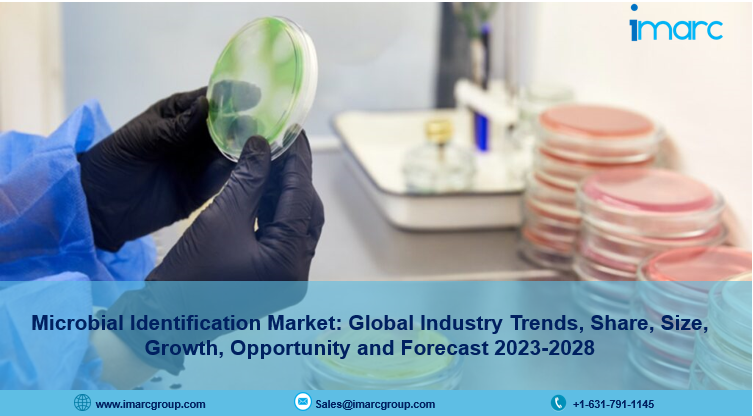

IMARC Group's report titled “Microbial Identification Market: Global Industry Trends, Share, Size, Growth, Opportunity and Forecast 2023-2028“, The global microbial identification market size reached US$ 4.1 Billion in 2022. Looking forward, IMARC Group expects the market to reach US$ 8.3 Billion by 2028, exhibiting a growth rate (CAGR) of 11.48% during 2023-2028.
Microbial identification refers to the process of determining and classifying microorganisms, such as bacteria, fungi, viruses, or other microorganisms, to the species or strain level. It involves identifying the specific type of microorganism present in a sample, which could be obtained from various sources such as clinical specimens, food, water, environmental samples, or industrial products. It helps identify spoilage organisms, pathogens, and indicators of poor hygiene or contamination during production, processing, or storage. It is used to ensure the safety and quality of food and beverages. It is also utilized in healthcare settings for diagnosing and treating infectious diseases.
For an in-depth analysis, you can refer sample copy of the report: https://www.imarcgroup.com/microbial-identification-market/requestsample
Microbial Identification Market Trends and Drivers:
The increasing use of microbial identification in the food and beverage (F&B) industry to ensure the safety and quality of products, identify potential pathogens and spoilage microorganisms of products and prevent foodborne illnesses represents one of the primary factors bolstering the market growth around the world. Moreover, the rising adoption of microbial identification in pharmaceutical and biotechnology industries for quality control, process monitoring, and product safety is favoring the growth of the market. Apart from this, the growing usage of microbial identification in environmental monitoring to assess microbial populations in various settings, such as water and wastewater treatment plants, agricultural systems, and environmental impact assessments, is influencing the market positively.
Report Segmentation:
The report has segmented the market into the following categories:
- Breakup by Products and Services:
- Instruments and Software
- Consumables
- Panels/ID Cards and Media
- Kits
- Others
- Services
- Breakup by Technology:
- Mass Spectrometry
- PCR
- Flow Cytometry
- Microscopy
- Others
- Breakup by Method:
- Phenotypic Methods
- Genotypic Methods
- Proteomics-Based Methods
- Breakup by Application:
- Diagnostics
- Food and Beverage Testing
- Pharmaceuticals
- Cosmetics and Personal Care Products Testing
- Others
Market Breakup by Region:
- North America (United States, Canada)
- Asia Pacific (China, Japan, India, South Korea, Australia, Indonesia, Others)
- Europe (Germany, France, United Kingdom, Italy, Spain, Russia, Others)
- Latin America (Brazil, Mexico, Others)
- Middle East and Africa
Competitive Landscape with Key Player:
- Beckman Coulter Inc. (Danaher Corporation)Biolog Inc.
- BioMerieux SA
- Bruker Corporation
- Charles River Laboratories International Inc.
- Eurofins Scientific SE
- Liofilchem S.r.l
- Merck KGaA
- Shimadzu Corporation
- Thermo Fisher Scientific Inc.
- VWR International LLC. (Avantor Inc.)
- Wickham Micro Limited.
If you need specific information that is not currently within the scope of the report, we will provide it to you as a part of the customization.
About Us
IMARC Group is a leading market research company that offers management strategy and market research worldwide. We partner with clients in all sectors and regions to identify their highest-value opportunities, address their most critical challenges, and transform their businesses.
IMARC’s information products include major market, scientific, economic and technological developments for business leaders in pharmaceutical, industrial, and high technology organizations. Market forecasts and industry analysis for biotechnology, advanced materials, pharmaceuticals, food and beverage, travel and tourism, nanotechnology and novel processing methods are at the top of the company’s expertise.
Contact US:
IMARC Group
134 N 4th St. Brooklyn, NY 11249, USA
Email: [email protected]
Tel No:(D) +91 120 433 0800
United States: +1-631-791-1145 | United Kingdom: +44-753-713-2163

Comments